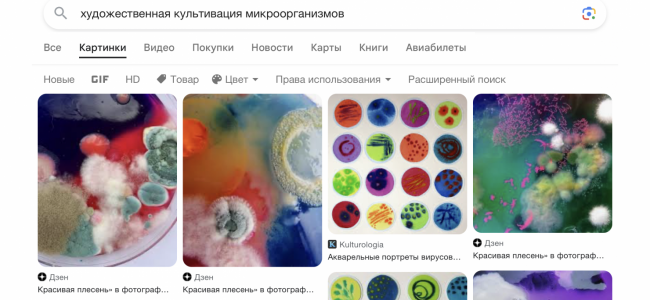
IMG_1440.png

- 22 Сен 2023
- 879
- 3,054
-
- 2
эт
а вот на даче как раз исковерканные
а по факту…. у меня везде уже по баночке есть…
а крупно - это 1?
о в городе норм. у них похоже нет обоняния.Самое жесткое это сухой вес ) его вывезти в первую очередь Настен , с соседями дружить надо какие твари они бы не были![]()
а вот на даче как раз исковерканные
а по факту…. у меня везде уже по баночке есть…
а крупно - это 1?